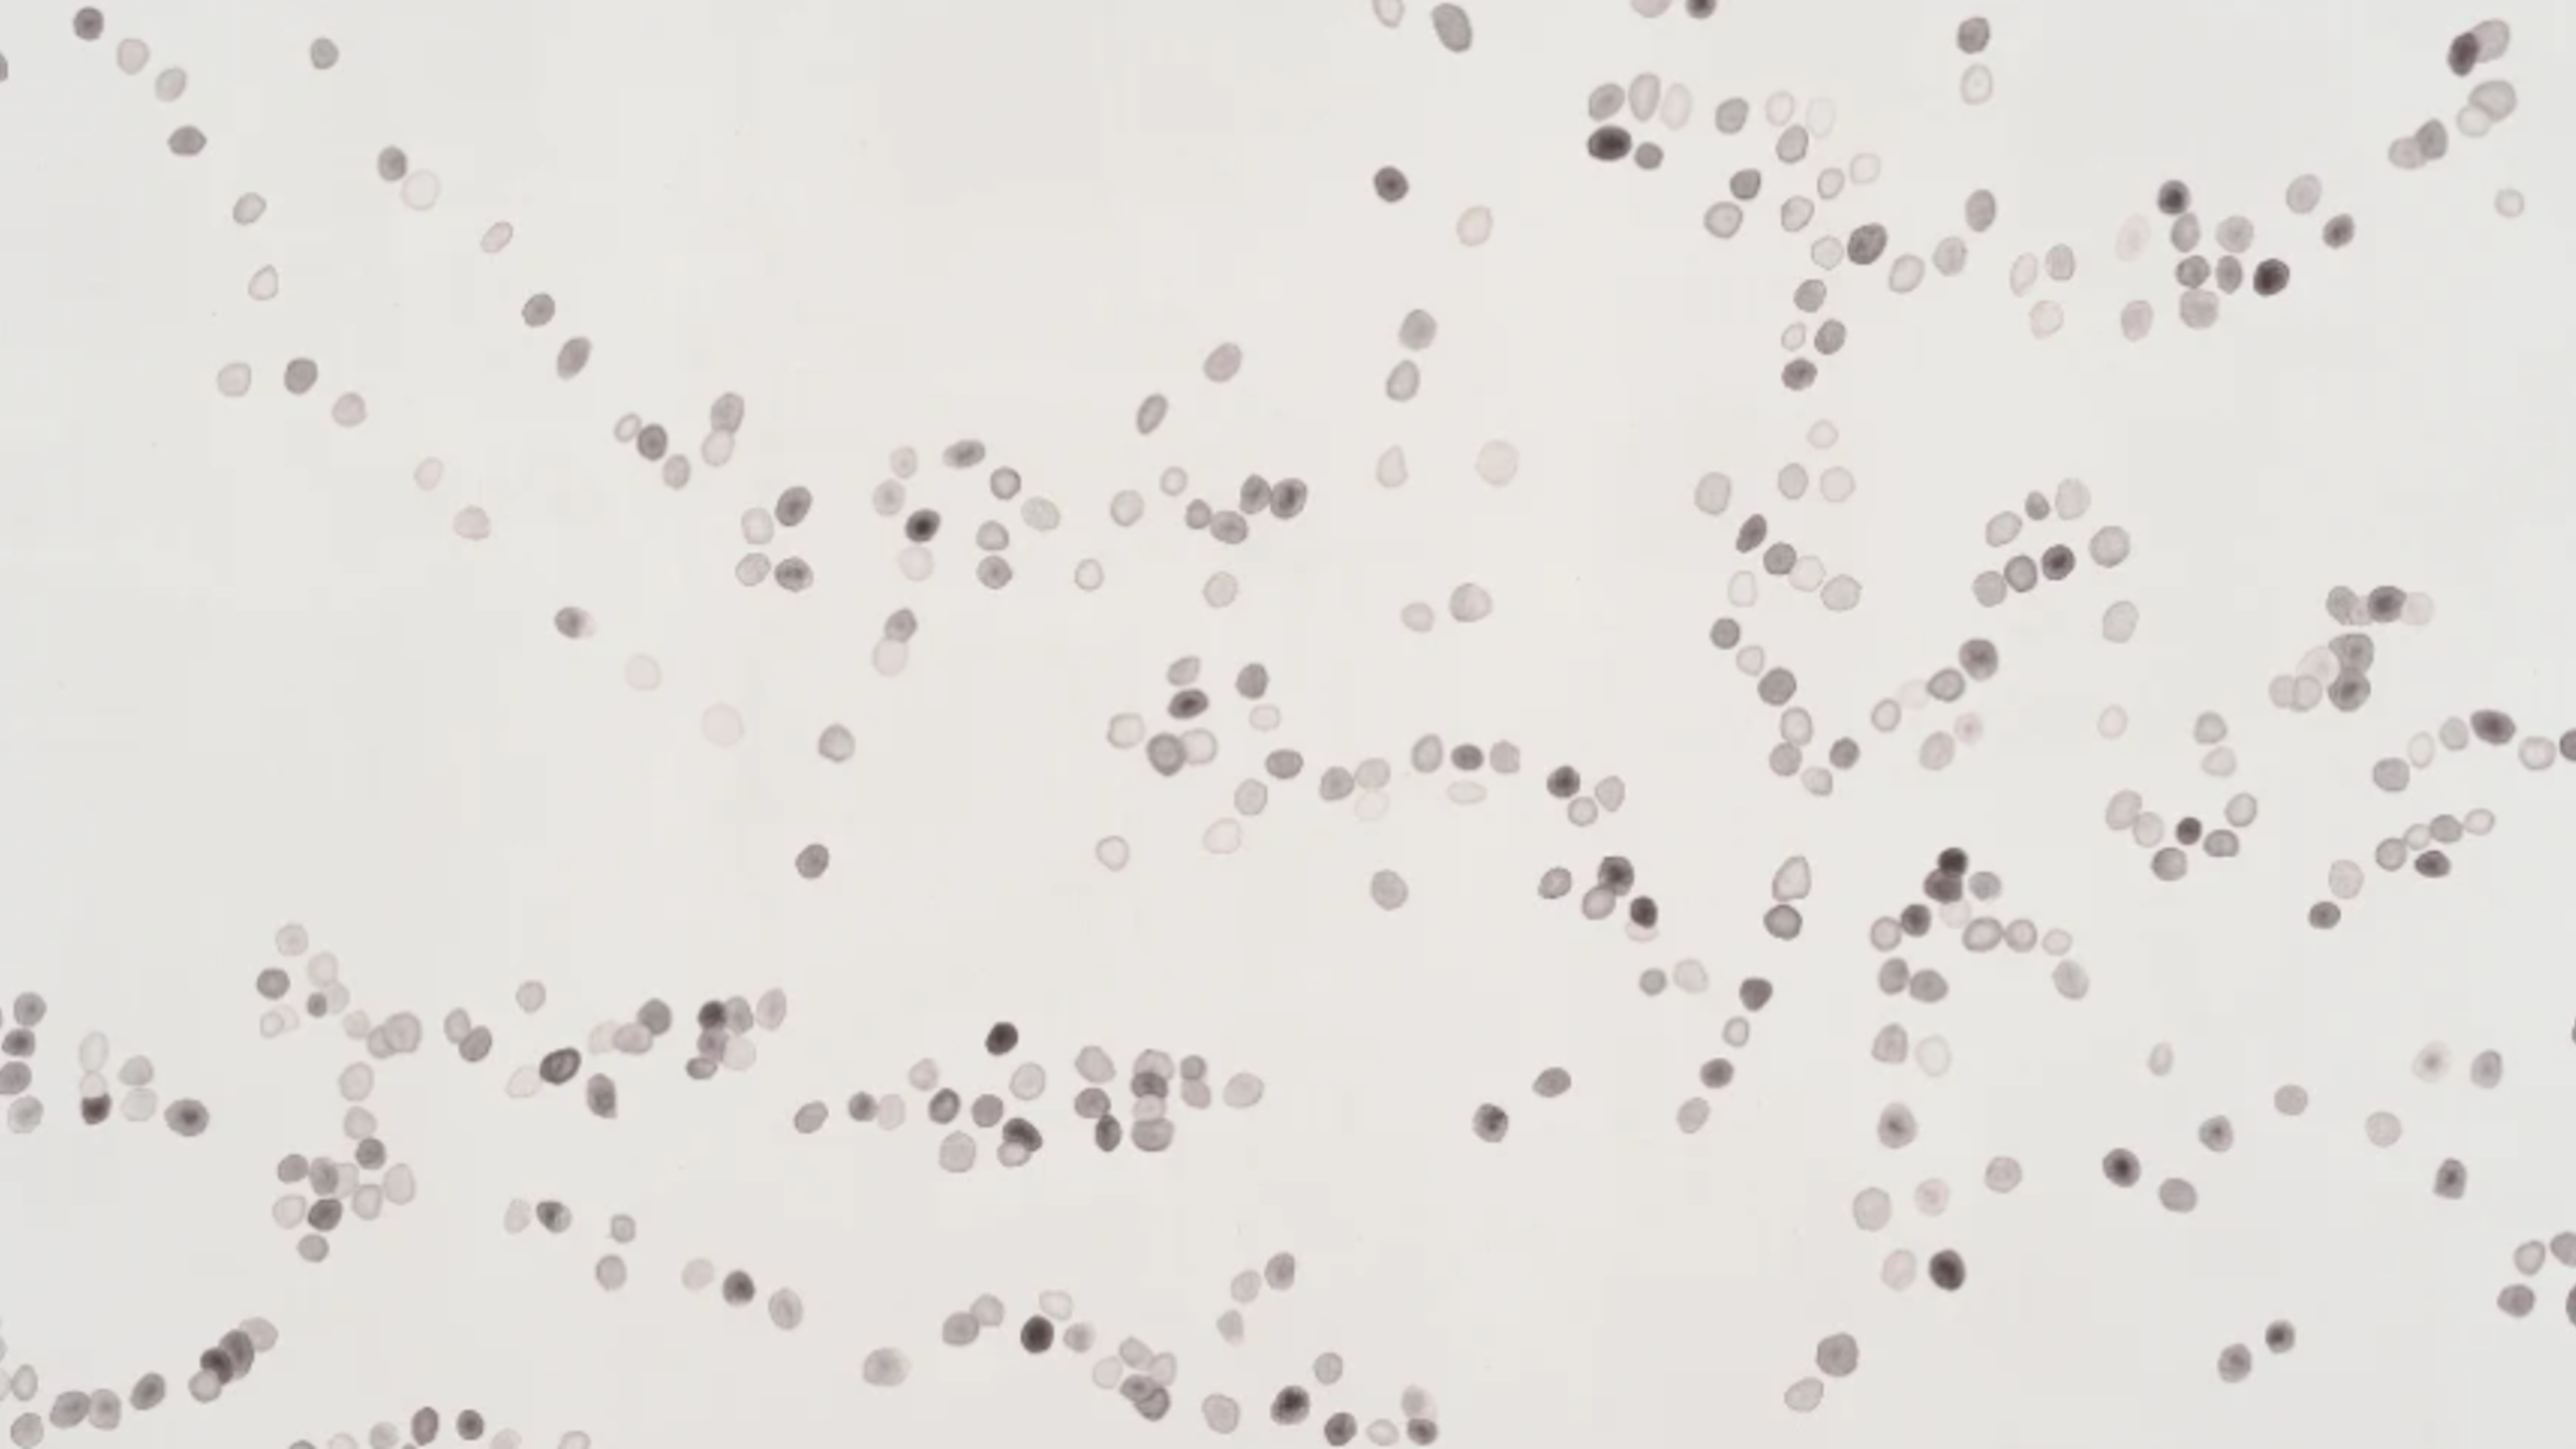
Crab Pellets

Labor
Location
Mexico CityFrancisco Ramíres #5 Col. Daniel Garza Miguel Hidalgo, 11830 Mexico City - Mexico
About
Founded by Pamela Echeverría in Mexico City, LABOR opened in 2009 working with artists whose creative processes are based on long term research. They have a strong commitment with the visions and concerns that their artists have towards the contemporary social/political context. They work with a mix of young and mid-career artists, both Mexican and international. With whom they work closely and assume an active role in the projects they develop. The work of these artists address topics such as value and exchange; economic systems and social structures; the exploitation of natural resources, the ethics of human behaviour, and the hidden political structures of society. ...
Labor: Artists
Labor: Artworks

?_a=BAVAZGID0)
?_a=BAVAZGID0)































?_a=BAVAZGID0)
?_a=BAVAZGID0)
?_a=BAVAZGID0)
?_a=BAVAZGID0)































